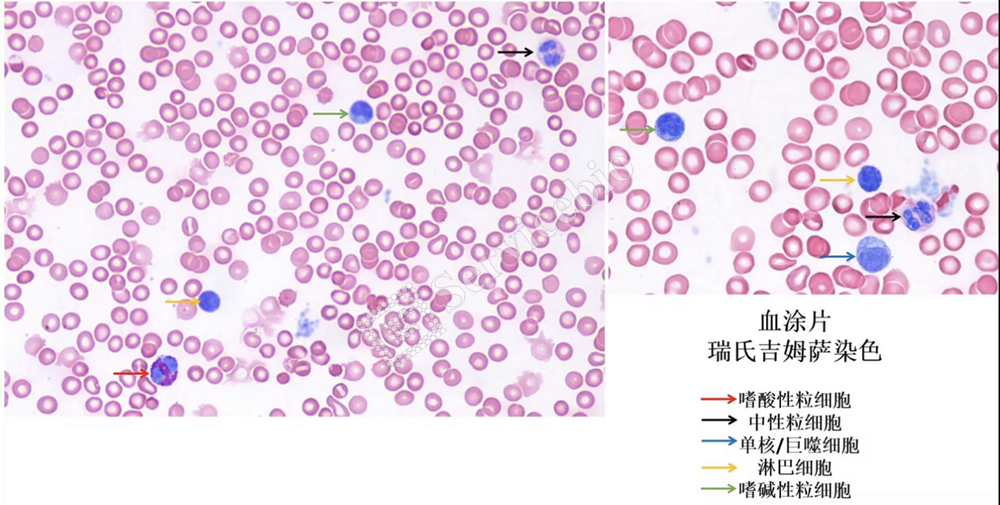
图片 1.jpg

改良吉姆萨染色
- 张
服务介绍:
组织切片及细胞涂片经吉姆萨染色后,各类细胞由于其成份的差异而呈现出不同的着色,从而达到分辨各类细胞的目的。本项目为改良吉姆萨染色,适用于血涂片,肺泡灌洗液细胞滴片,骨髓细胞涂片,石蜡切片和冰冻切片的染色,染色目的多为观察各类炎性细胞的特征及数量分布。
实验结果展示:

小鼠肺泡灌洗液涂片,未裂解红细胞

实验流程:
涂片/组织切片-改良吉姆萨染色-脱水封片-显微镜镜检
结果判读:
细胞类型 | 细胞特征及染色结果 |
成熟红细胞 | 圆饼状,粉红色,无核 |
中性粒细胞 | 细胞核蓝色,呈马蹄形,杆状或分叶形;胞质淡紫红色 |
嗜酸性颗粒 | 细胞核蓝色,呈马蹄形,杆状或分叶形;胞质内深红色颗粒 |
嗜碱性粒细胞 | 细胞核蓝色,呈马蹄形,杆状或分叶形;胞质内蓝紫色颗粒 |
淋巴细胞 | 细胞较小,核蓝色小而圆;细胞质较少呈蓝紫色 |
单核细胞/巨噬细胞 | 细胞较大,细胞核蓝色大而圆;细胞质浅蓝紫色 |
样本准备方法及送样运输要求(为保证染色成功率,血液、肺泡灌洗液建议客户按以下方法自行涂片固定后送样):
1.涂片的制作方法:
1.1 血涂片制备:
(1)取新鲜血液(若用抗凝管收集的血液,放置最好不要超过24 h,否则血液中白细胞的数量以及种类会明显减少),选用干净的粘附玻片,用移液枪吸取10 μL的血液,滴加在玻片的一侧(一般为磨砂对侧)。
(2)再取一片辅助玻片(也可选用盖玻片,依据个人手的力道习惯选择),以45°角将其宽边靠近血液,血液沿着接触边缘向两边晕开,当两边都到达边缘时,轻轻地稳健且匀速地推向磨砂面一侧,进行涂片,然后快速果断地拿走载玻片,可见涂片首尾分明,厚薄均匀。(一般在保证涂抹速度力道适中的情况下,取走辅助玻片时载玻片上的血几乎无残留,且涂抹出的血涂片细胞无明显破碎、变形。在显微镜下可观察到细胞呈单个紧密排列,整体比较均匀。)
(3)自然晾干后,用甲醇浸泡固定15 min,自然晾干后4℃保存运输。
1.2 肺泡灌洗液涂片制备:
(1)取肺泡灌洗液悬液1500 rpm 4℃离心10 min去上清。
a、若肉眼观察无明显细胞沉淀,弃上清留离心管底部少量液体直接加入50 μL卡诺氏固定液轻柔吹打重悬、室温固定15 min,固定过程中可晃动离心管,避免细胞沉淀沉降离心管底部导致固定不充分,固定后用移液枪吹打混匀,涂于粘附载玻片上提前用组化笔画好的小圆圈中(3 cm×2 cm的椭圆);
b、若细胞沉淀量很多,黄豆大小或更大,弃上清后加入500 μL卡诺氏固定液固定细胞沉淀15 min,固定过程中可晃动离心管,避免细胞沉淀沉降离心管底部导致固定不充分,固定后的细胞沉淀1500 rpm离心5 min弃固定液,用PBS或生理盐水重新重悬细胞沉淀,取200 μL悬液,涂于粘附载玻片上提前用组化笔画好的大圆圈中(最大长边约5 cm,最大短边约2 cm的椭圆)。在显微镜下观察细胞量的多少,若还是过厚,再用PBS对倍稀释该细胞悬液,直至在显微镜下观察到细胞量涂布均匀。
(2)用移液枪将细胞悬液铺满整个组化笔圈内,涂片放置自然晾干(不可通过烘箱加快晾干)。
(3)将晾干后的涂片,自然风干,4℃保存运输。
2. 石蜡切片常温运输,冰冻切片-20℃运输。
样本种类 | 预处理过程 | 固定条件 | 保存运输条件 | 备注 |
血液 | 5-10 μL 血液涂片 | 甲醇固定15 min后自然晾干 | 4℃保存运输 | 血液要用EDTA抗凝管采集,新鲜血液需取血后立即涂片固定。 |
肺泡灌洗液 | 50-150 μL细胞悬浮液涂片 |
卡诺氏固定液固定15 min后自然晾干 | 4℃保存运输 | 肺泡灌洗液取样时,灌洗动作要轻柔,不能使肺脏出血,灌洗力度过大会造成一部分细胞形态破裂。 |
3. 骨髓细胞样本、细胞涂片样本需要客户自行制作涂片,涂片后甲醇固定15 min,自然干燥后,将晾干的涂片,4℃保存运输。(细胞样本1000rpm离心5 min后进行涂片)
仅供科研用途,不可用于临床诊断!
| 货号 | 名称 | 规格 | 价格 | 操作 |
|---|
| 货号 | 名称 | 规格 | 价格 | 操作 |
|---|


